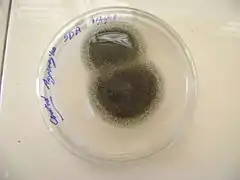

Aspergillus niger
Аспергіл чорний (Aspergillus niger) — вид грибів роду аспергіл (Aspergillus). Сучасну біномінальну назву надано у 1867 році.[8]
? Aspergillus niger | ||||||||||||||||||||||
|---|---|---|---|---|---|---|---|---|---|---|---|---|---|---|---|---|---|---|---|---|---|---|
 | ||||||||||||||||||||||
| Біологічна класифікація | ||||||||||||||||||||||
| ||||||||||||||||||||||
| Aspergillus niger Tieghem, 1867 | ||||||||||||||||||||||
| Синоніми | ||||||||||||||||||||||
| Sterigmatocystis nigra (Tiegh.) Tiegh., [1] Aspergillopsis nigra (Tiegh.) Speg., [2] | ||||||||||||||||||||||
Посилання | ||||||||||||||||||||||
| ||||||||||||||||||||||
Будова
Зустрічається у формі чорної цвілі. Колонії ростуть швидко за 37 0С, спочатку білі, потім жовтіють і на 2-3 добу формують повітряний міцелій чорного кольору. Реверс колоній світло-жовтий.
За мікроскопії: дворядні конідіальні ґоловки, спори закруглені у ланцюжках, 4-5 мкм у діаметрі.
Поширення та середовище існування
Дуже поширений цвілевий гриб, який можна зустріти у ванних кімнатах та продуктах харчування.
Практичне використання
Використовують за виробництва харчових додатків E330, E574, для виробництва сидру та очищення вина, є основним агентом ферментації чаю пуер.
2-6 % інвазивних аспергільозів викликані даним видом гриба.
Див. також
Галерея
 На цибулі
На цибулі В лабораторії
В лабораторії Грибниця всередині випотрошеного кабака
Грибниця всередині випотрошеного кабака
Примітки
- Bulletin de la Société Botanique de France 24: 102 (1877)
- Anales del Museo Nacional de Historia Natural Buenos Aires 20 (13): 435 (1910)
- (1911)
- Bulletin of the Buffalo Society of Natural Sciences 1: 69 (1873)
- (1912)
- Mutationen bei Aspergillus niger v. Tieghem, Inaugural-Diss (1912)
- (1916)
- Aspergillus niger. www.mycobank.org. Процитовано 2017-03-30T19:21:44+00:00.
Джерела
- Aspergillus niger // Mycobank.org, — CBS-KNAW Fungal Biodiversity Center Utrecht, 2016. — URL
- Tieghem, P. van. 1867. Description d'une nouvelle espèce d'Aspergillus: A. niger. Annales des Sciences Naturelles Botanique. 8:240-244
- МЕДИЧНА МIКРОБIОЛОГIЯ, ВIРУСОЛОГIЯ ТА IМУНОЛОГIЯ // Андріанова Т. В., Бобир В. В., Виноград Н. О., Войцеховський В. Г., Данилейченко В. В., Дзюблик І. В., Димент Г. С., Євтушенко О. І., Климнюк С. І., Коваль Е. З., Ковальчук В. П., Кременчуцький Г. М., Криворутченко Ю. Л., Ліпатнікова К. І., Мінухін В. В., Нехороших З. М., Олексієнко І. П., Палій В. Г., Палій Г. К., Руденко А. В., Салата О. В., Тарасов Т. Н., Федечко Й. М., Циганенко А. Я., Шилов М. В., Широбоков В. П., Якименко А. І., Янковський Д. С. / Нова Книга — 952 стор. — С. 684